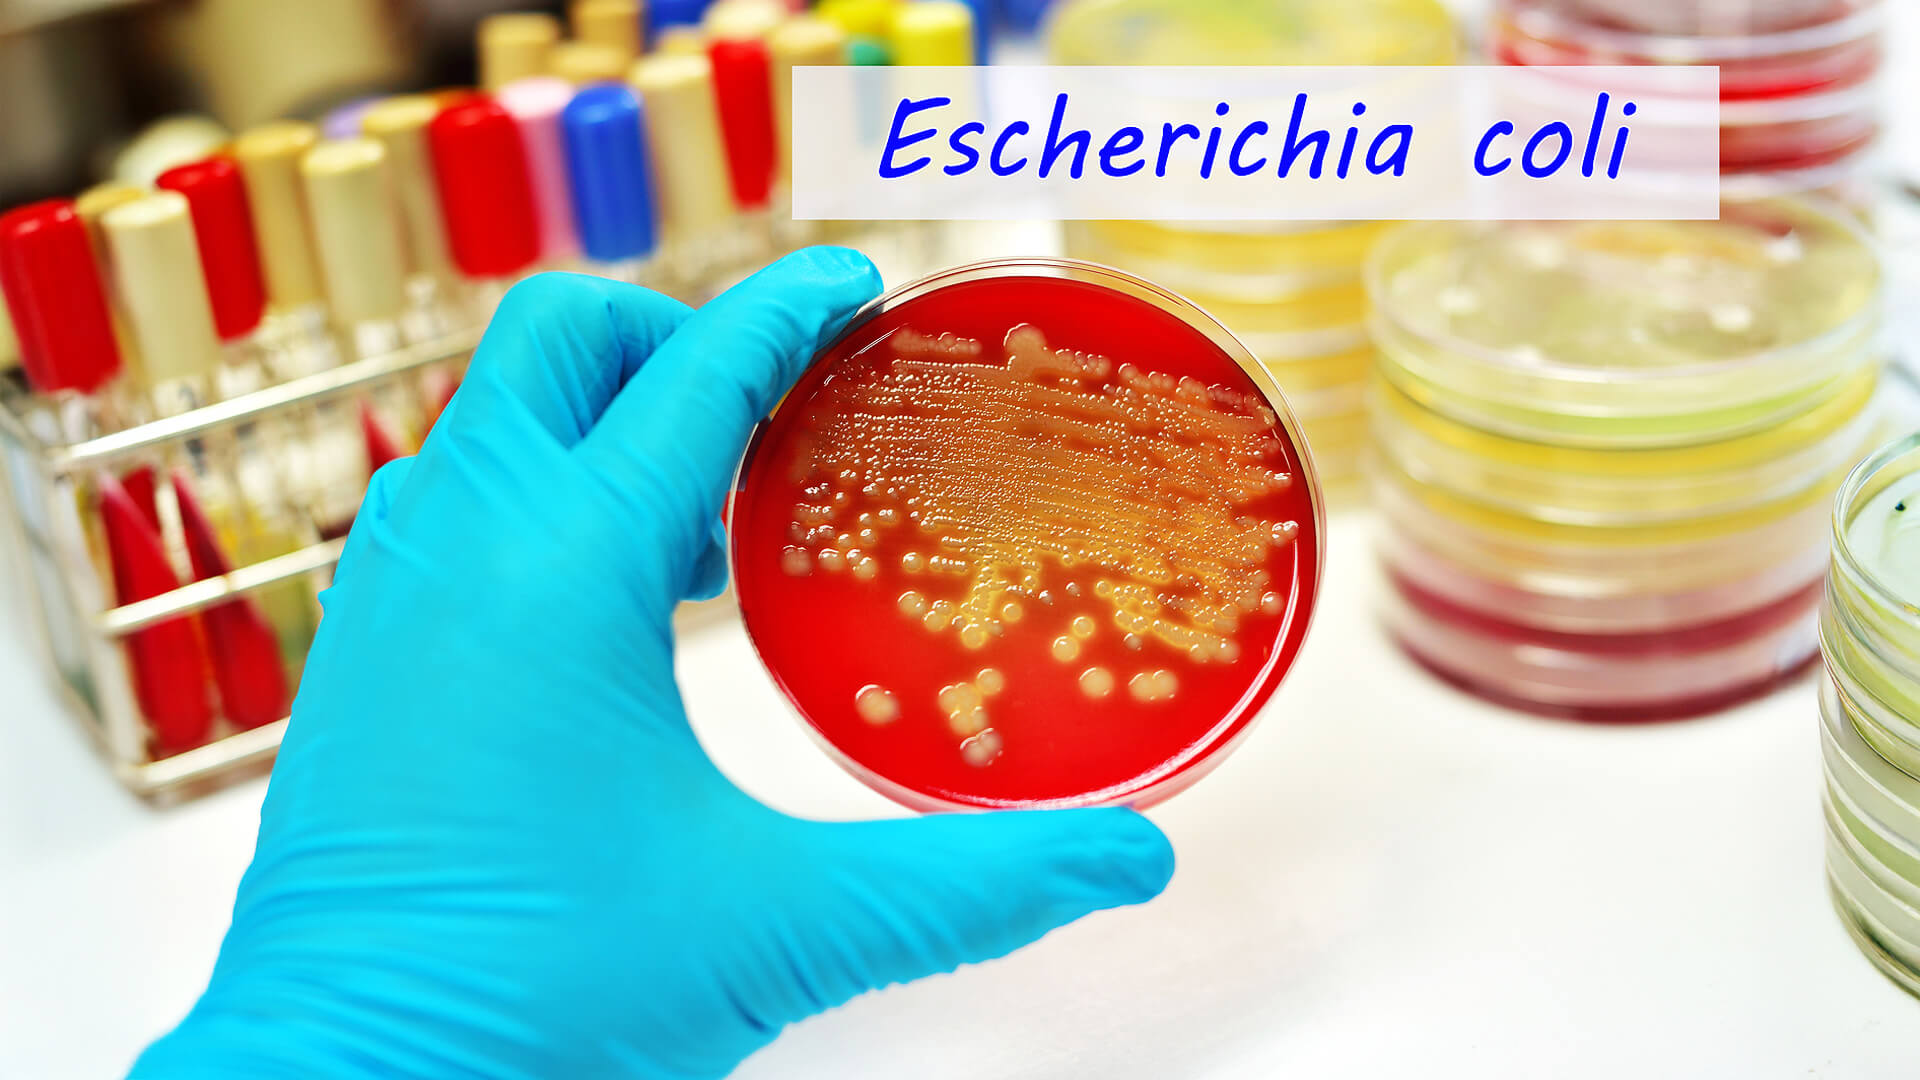

- Теодора Тодорова
- Грижа за косата, кожата и ноктите , Полезни съвети , Полезно
- 0 коментари
- Тагове: ешерихия коли
Съдържание
Как можем да се заразим
Патогенните щамове обикновено се предават чрез животни, при консумация на недобре обработени хранителни продукти (особено мляко и месо), замърсени сурови зеленчуци или вода.
Възможно е нормално живеещите в червата бактерии да попаднат и на места като пикочните пътища, в носа или в урината, и това да доведе до автоинфекция. Инкубационният период за повечето щамове E. coli е от 10 часа до 6 дни.
Ешерихия коли може да бъде заразна, когато се разпространява от човек на човек чрез лоша хигиена – при мръсни ръце, или при докосване на предмети, повърхности или храна, които са били в контакт с инфектиран. Това повдига въпроса - заразно ли е заболяването? Отговорът е да, особено при неправилна хигиена.
Кои са рисковите фактори
При наличие на стабилен имунитет човек обикновено успява да се пребори с патогенната E. coli преди появата на симптомите. Някои обаче са изложени на по-голям риск от заразяване от други:
- хора над 65г
- консумирали недопечено месо или сурово мляко и непастьоризиран сок
- хора с понижени нива на стомашна киселина поради прием на лекарства
- новородени и много малки деца
Стомашната киселина предпазва от E. coli. Трябва също да се отбележи, че жените по-лесно получават инфекции на пикочните пътища от мъжете. Друг рисков фактор е времето на годината. Заразяването с тази бактерия се случва най-често през летните месеци (юни-септември).
Какво причинява
Вредните щамове на бактерията при случайно поглъщане причиняват водниста диария, болки в стомаха и други храносмилателни симптоми (гастроентерит).
E. coli е най-честата причина за:
- Инфекции на пикочните пътища (особено при жените)
- Инфекция на кръвния поток
- Вътрекоремни инфекции (като перитонит), плюс инфекции на кожата и меките тъкани
- Инфекция на жлъчния мехур
- Инфекции на рани
- Вагинална и/или ендоцервикална колонизация
- Различни инфекции при бременни жени и родилки
- Неонатална инфекция (като ранен и късен неонатален сепсис)
- Остър или хроничен бактериален простатит при мъже (инфекция при мъжете)
- Проблеми в бъбреците, причинени от усложнена инфекция с E. coli
Разпознаване на симптомите
Шест от болестотворните щамове Escherichia coli причиняват диария. Най-честите симптоми са:
- висока температура
- повръщане
- стомашни болки
Някои от тези щамове могат да заразяват и пикочните пътища. Един от тях е особено опасен, тъй като може да доведе до увреждане на бъбреците.
При инфекции на пикочните пътища, при остър простатит например, симптомите включват:
- висока температура и втрисане
- болезнено и често уриниране
- тазова болка
- дискомфорт в долната част на гърба
- еректилна дисфункция
- преждевременна и болезнена еякулация
Как се лекува
Лечението на E. coli зависи от това коя част от тялото ви е заразена и колко сериозно е заболяването.
При диария:
- приемайте много течности, включително орален рехидратиращ разтвор
- може да смесите 1 част напитка с 4 части вода (напр. 40 ml напитка със 160 ml вода)
- не приемайте лекарства против повръщане или диария без лекарска препоръка
Повечето хора се възстановяват в рамките на 5 до 10 дни без лечение.
Антибиотиците се използват само при тежки симптоми или инфекция на пикочните пътища поради риска от антибиотична резистентност.
Какво унищожава Escherichia coli?
Термичната обработка е най-ефективният начин – готвене на месо до вътрешна температура от поне 70°C.
Избягвайте кръстосано замърсяване между сурови и готови храни.
Поддържайте добра лична хигиена и дезинфекция на кухненски повърхности.
Допълнително, в стомаха киселинната среда също има защитна роля, тъй като унищожава част от попадналите бактерии.
Предаване по полов път не е обичаен механизъм за заразяване, но в редки случаи и при определени сексуални практики е възможно.
Заключение
Ешерихия коли е често срещана, но в определени ситуации и условия може да бъде сериозен патоген. Познаването на начините на предаване, симптомите и методите за превенция е от ключово значение за поддържане на доброто здраве.
Прочети още










Коментари (0)
Нов коментар